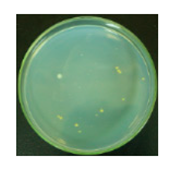
Materials 12 00127 i001
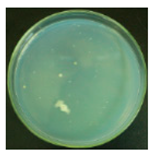
Materials 12 00127 i013
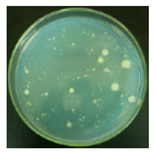
Materials 12 00127 i016

Disinfectant Performance of a Chlorine Regenerable Antibacterial Microfiber Fabric as a Reusable Wiper
Abstract
:1. Introduction
2. Material and Methods
2.1. Chemicals and Materials
2.2. Instrumentations
2.3. Chemical Finishing Process
2.4. Chlorination and Analytical Titration
2.5. Stability and Durability Testing
2.6. Qualitative Antibacterial Activity
2.7. Rechargeability of Fabrics
2.8. Quantitative Testing of Antibacterial Activity
3. Results and Discussion
3.1. Characterization and Stability
3.2. The Antibacterial Property
3.2.1. Qualitative Antibacterial Evaluation and Stability of Active Chlorine
3.2.2. Rechargeable Antibacterial Property
3.2.3. Rapid Antibacterial Function of Fabrics
3.2.4. Comparison with a Commercial Product in Antibacterial Functions
3.3. Factors Affecting Chlorine Recharging Efficiency
4. Conclusions
Author Contributions
Funding
Conflicts of Interest
References
- Neoh, K.G.; Li, M.; Kang, E.T.; Chiong, E.; Tambyah, P.A. Surface Modification Strategies for Combating Catheter-Related Complications: Recent Advances and Challenges. J. Mater. Chem. B. 2017, 5, 2045–2067. [Google Scholar] [CrossRef]
- Singha, P.; Locklin, J.; Handa, H. A Review of the Recent Advances in Antimicrobial Coatings for Urinary Catheters. Acta. Biomater. 2017, 50, 20–40. [Google Scholar] [CrossRef] [PubMed]
- Wei, T.; Tang, Z.C.; Yu, Q.; Chen, H. Smart antibacterial surfaces with switchable bacteria-killing and bacteria-releasing capabilities. ACS App. Mater. Interfaces 2017, 9, 35711–37523. [Google Scholar] [CrossRef] [PubMed]
- Jensen, D.A.; Danyluk, M.D.; Harris, L.J.; Schaffner, D.W. Quantifying the effect of hand wash duration, soap use, ground beef debris, and drying methods on the removal of Enterobacter aerogenes on hands. J. Food Protect. 2015, 78, 685–690. [Google Scholar] [CrossRef] [PubMed]
- Mollema, F.P.; Richardus, J.H.; Behrendt, M.; Vaessen, N.; Lodder, W.; Hendriks, W.; Verbrugh, H.A.; Vos, M.C. Transmission of methicillin-resistant Staphylococcus aureus to household contacts. J. Clin. Microbiol. 2010, 48, 202–227. [Google Scholar] [CrossRef] [PubMed]
- Angen, Ø.; Feld, L.; Larsen, J.; Rostgaard, K.; Skov, R.; Madsen, A.M.; Larsen, A.R. Transmission of MRSA to human volunteers visiting a swine farm. Appl. Environ. Microb. 2017, 83, e01489-17. [Google Scholar] [CrossRef] [PubMed]
- Sun, G. Prevention of hospital and community acquired infections by using antibacterial textiles and clothing. In Polymeric Materials with Antimicrobial Activity; Muñoz-Bonilla, A., Cerrada, M., Fernández-García, M., Eds.; The Royal Society of Chemistry: Cambridge, UK, 2013; ISBN 978-1-84973-807-1. [Google Scholar]
- Li, Q.S.; Li, Y.; Ma, Z.G.; Xin, T.F. Study on structure and properties of profiled polyester fiber. Syn. Fiber. China 2009, 17, 15–18. [Google Scholar] [CrossRef]
- Nilsen, S.K.; Dahl, I.; Jørgensen, O.; Schneider, T. Micro-fibre and ultra-micro-fibre cloths, their physical characteristics, cleaning effect, abrasion on surfaces, friction, and wear resistance. Build. Environ. 2002, 37, 1373–1378. [Google Scholar] [CrossRef]
- Gao, M.; Zhu, P.; Dong, Y. Evaluation of cleaning functions of fabrics made of superfine fibers. J. Text. Res. 2007, 28, 27–30. [Google Scholar] [CrossRef]
- Diab-Elschahawi, M.; Assadian, O.; Blacky, A.; Stadler, M.; Pernicka, E.; Berger, J.; Resch, H.; Koller, W. Evaluation of the decontamination efficacy of new and reprocessed microfiber cleaning cloth compared with other commonly used cleaning cloths in the hospital. Am. J. Infect. Control. 2010, 38, 289–292. [Google Scholar] [CrossRef] [PubMed]
- Rutala, W.A.; Gergen, M.F.; Weber, D.J. Microbiologic evaluation of microfiber mops for surface disinfection. Am. J. Infect. Control. 2007, 35, 569–573. [Google Scholar] [CrossRef] [PubMed]
- Gulumser, D.; Burak, Y.; Iberia, A.; Tugce, G.; Ahmet, H.C.; Huseyin, S.; Sema, P. Functionalization of cotton fabric with nanosized TiO2 coating for self-cleaning and antibacterial property enhancement. J. Coat. Technol. Res. 2016, 13, 257–265. [Google Scholar] [CrossRef]
- Li, R.; Dou, J.F.; Jiang, Q.Y.; Li, J.; Xie, Z.W.; Liang, J.; Ren, X.H. Preparation and antimicrobial activity of β-cyclodextrin derivative copolymers/cellulose acetate nanofibers. Chem. Eng. J. 2014, 248, 264–272. [Google Scholar] [CrossRef]
- Chen, X.Q.; Liu, Z.L.; Cao, W.W.; Yong, C.Y.; Xing, X.D. Preparation, characterization, and antibacterial activities of quaternarized N-halamine-grafted cellulose fibers. J. Appl. Polym. Sci. 2015, 132, 42702–42709. [Google Scholar] [CrossRef]
- Cheng, X.L.; Ma, K.K.; Li, R.; Ren, X.H.; Huang, T.S. Antimicrobial coating of modified chitosan onto cotton fabrics. Appl. Surf. Sci. 2014, 309, 138–143. [Google Scholar] [CrossRef]
- Vitiello, G.; Silvestri, B.; Luciani, G. Learning from nature: bioinspired strategies towards antimicrobial nanostructured systems. Curr. Top. Med. Chem. 2018, 18, 22–41. [Google Scholar] [CrossRef]
- Vitiello, G.; Pezzella, A.; Zanfardino, A.; Varcamonti, M.; Silvestri, B.; Costantini, A.; Branda, F.; Luciani, G. Titania as a driving agent for DHICA polymerization: A novel strategy for the design of bioinspired antimicrobial nanomaterials. J. Mater. Chem. B 2015, 14, 2808–2815. [Google Scholar] [CrossRef]
- Kang, C.K.; Kim, S.S.; Kim, S.; Lee, J.; Roh, C.; Lee, J. Antibacterial cotton fibers treated with silver nanoparticles and quaternary ammonium salts. Carbohyd. Polym. 2016, 151, 1012–1018. [Google Scholar] [CrossRef]
- Shahidi, S.; Wiener, J. Antibacterial agents in textile industry. In Antimicrobial Agents; Bobbarala, V., Ed.; InTech: London, UK, 2012; pp. 387–406. ISBN 978-953-51-0723-1. [Google Scholar]
- Simoncic, B.; Tomsic, B. Structures of novel antimicrobial agents for textiles. Text. Res. J. 2010, 80, 1721–1737. [Google Scholar] [CrossRef]
- Pan, N.; Sun, G. Functional Textiles for Improved Performance, Protection and Health; Woodhead Publishing Limited: Cambridge, UK, 2011; pp. 360–372. ISBN 978-0-85709-287-8. [Google Scholar]
- Liu, S.; Sun, G. Radical graft functional modification of cellulose with allyl monomers: Chemistry and structure characteerization. Carbohyd. Polym. 2008, 71, 614–625. [Google Scholar] [CrossRef]
- Liu, S.; Sun, G. Functional modification of poly(ethylene terephthalate) with an allyl monomer: Chemical and structure characterization. Polymer 2008, 49, 5225–5232. [Google Scholar] [CrossRef]
- Sun, Y.Y.; Sun, G. Novel regenerable N-halamine polymeric boicides. I. synthesis, characterization, and antibacterial activity of hydantoin-containing polymers. J. Appl. Polym. Sci. 2001, 80, 2460–2467. [Google Scholar] [CrossRef]
- Sun, Y.Y.; Sun, G. Novel regernerable N-halamine polymeric biocides. III. Grafting hydantoin-containing monomers onto synthetic fabrics. J. Appl. Polym. Sci. 2001, 81, 1517–1525. [Google Scholar] [CrossRef]
- Sun, Y.Y.; Sun, G. Durable and regenerable antimicrobial textile materials prepared by a continuous grafting process. J. Appl. Polym. Sci. 2002, 84, 1592–1599. [Google Scholar] [CrossRef]
- Tamizifar, M.; Sun, G. Control of surface radical graft polymerization on polyester fibers by using Hansen solubility parameters as a measurement of the affinity of chemicals to materials. RSC Adv. 2017, 13299–13303. [Google Scholar] [CrossRef]
- Liu, Y.; Liu, Y.; Ren, X.H.; Huang, T.S. Antimicrobial cotton containing N-halamine and quaternary ammonium groups by grafting copolymerization. Appl. Surf. Sci. 2014, 296, 231–236. [Google Scholar] [CrossRef]
- Tamizifar, M.; Sun, G. Surface modification of poly(ethylene terephthalate) fibers via controlled radical graft polymerization. J. Appl. Polym. Sci. 2017, 135, 45990. [Google Scholar] [CrossRef]
- Tamizifar, M.; Sun, G. Controlled Surface Functionalization of Poly(ethylene terephthalate) Fibers with Varied Vinyl Monomers via Radical Graft Copolymerization. Mater. Today Commun. 2018, 17, 124–132. [Google Scholar] [CrossRef]
- Sun, G.; Worley, S.D. Chemistry of durable and regenerable biocidal textiles. J. Chem. Educ. 2005, 82, 60–64. [Google Scholar] [CrossRef]
- Worley, S.D.; Williams, D.E.; Crawford, R.A. Halamine water disinfectants. Crit. Rev. Environ. Control 1988, 18, 133–175. [Google Scholar] [CrossRef]
- Sun, G.; Worley, S.D. Halamine Chemistry and Its Applications in Biocidal Textiles and Polymers. In Modified Fibers with Medical and Specialty Applications; Springer: Dordrecht, The Netherlands, 2006; pp. 81–89. [Google Scholar]







| Before Testing | Number of Cleaning Tables * | 1 | 10 | 20 | 30 | |
|---|---|---|---|---|---|---|
![]() | Antibacterial fabrics | Tables | ![]() | ![]() | ![]() | ![]() |
| Fabrics | ![]() | ![]() | ![]() | ![]() | ||
| Untreated fabrics | Tables | ![]() | ![]() | ![]() | ![]() | |
| Fabrics | ![]() | ![]() | ![]() | ![]() | ||
| Repetition | Antibacterial Property | Active Chlorine (ppm) | ||
|---|---|---|---|---|
| Tables | Fabrics | Dry | Wet | |
| 1 | ![]() | ![]() | 454.3 ± 15.3 | 2142.1 ± 31.2 |
| 2 | ![]() | ![]() | 432.2 ± 13.6 | 2135.3 ± 40.9 |
| 3 | ![]() | ![]() | 448.7 ± 10.5 | 2123.9 ± 38.4 |
| 4 | ![]() | ![]() | 413.6 ± 9.8 | 2101.2 ± 34.7 |
| 5 | ![]() | ![]() | 426.6 ± 12.9 | 2094.7 ± 19.6 |
| Contact Time (min) | Reduction of S. aureus a | Reduction of E. coli b | ||
|---|---|---|---|---|
| % | Log | % | Log | |
| 0.5 | 85 | 0.82 | 88 | 0.92 |
| 1 | 95 | 1.30 | 94 | 1.22 |
| 3 | 100 | 5.40 | 100 | 5.34 |
| 5 | 100 | 5.40 | 100 | 5.34 |
| 10 | 100 | 5.40 | 100 | 5.34 |
| 30 | 100 | 5.40 | 100 | 5.34 |
| Washing Times | ADMH | Reputex-48 | ||||||
|---|---|---|---|---|---|---|---|---|
| S. aureusa | E. colib | S. aureusa | E. colib | |||||
| % | Log | % | Log | % | Log | % | Log | |
| 1 | 100 | 5.35 | 100 | 5.35 | 100 | 5.36 | 100 | 5.36 |
| 3 | 100 | 5.35 | 100 | 5.35 | 100 | 5.36 | 100 | 5.36 |
| 5 | 100 | 5.35 | 100 | 5.35 | 85 | 0.82 | 89 | 0.96 |
| 7 | 100 | 5.35 | 100 | 5.35 | 73 | 0.57 | 75 | 0.60 |
| 8 | 100 | 5.35 | 100 | 5.35 | 70 | 0.52 | 69 | 0.51 |
| 9 | 100 | 5.35 | 100 | 5.35 | 64 | 0.44 | 61 | 0.41 |
| 10 | 100 | 5.35 | 100 | 5.35 | 58 | 0.38 | 55 | 0.35 |
© 2019 by the authors. Licensee MDPI, Basel, Switzerland. This article is an open access article distributed under the terms and conditions of the Creative Commons Attribution (CC BY) license (http://creativecommons.org/licenses/by/4.0/).
Share and Cite
Huang, C.; Chen, Y.; Sun, G.; Yan, K. Disinfectant Performance of a Chlorine Regenerable Antibacterial Microfiber Fabric as a Reusable Wiper. Materials 2019, 12, 127. https://doi.org/10.3390/ma12010127
Huang C, Chen Y, Sun G, Yan K. Disinfectant Performance of a Chlorine Regenerable Antibacterial Microfiber Fabric as a Reusable Wiper. Materials. 2019; 12(1):127. https://doi.org/10.3390/ma12010127
Chicago/Turabian StyleHuang, Cheng, Yongbang Chen, Gang Sun, and Kelu Yan. 2019. "Disinfectant Performance of a Chlorine Regenerable Antibacterial Microfiber Fabric as a Reusable Wiper" Materials 12, no. 1: 127. https://doi.org/10.3390/ma12010127
APA StyleHuang, C., Chen, Y., Sun, G., & Yan, K. (2019). Disinfectant Performance of a Chlorine Regenerable Antibacterial Microfiber Fabric as a Reusable Wiper. Materials, 12(1), 127. https://doi.org/10.3390/ma12010127